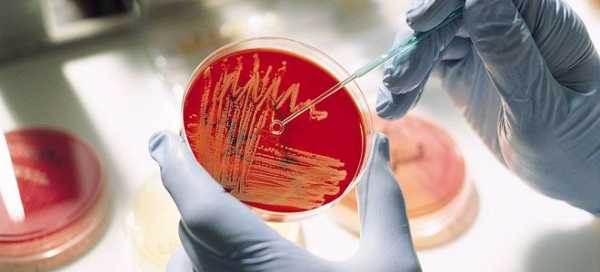

Кишечная инфекция – все виды и лучшие способы лечения

Так как кишечник отвечает за всасывание из пищи полезных веществ и передачу их в кровь, заболевания этого органа приводят к резкому ухудшению самочувствия и проблемам в работе других органов. Самой распространенной болезнью ЖКТ является кишечная инфекция, требующая быстрого и правильного лечения.
Инфекции кишечника – виды
Хотя причины кишечных инфекций могут быть самые разнообразные, всех их можно разделить на три крупные группы:
- Вирусные инфекции. Возбудителем инфекции является вирус, передающийся воздушно-капельным путем. Вирусные инфекции вызываются десятками возбудителей, среди которых самыми распространенными являются такие: ротавирусные, энтеровирусные, аденовирусные.
- Бактериальные инфекции. Этот вид инфекции провоцируется такими возбудителями, как кишечная палочка, сальмонелла, дизентерийная палочка, стафилококк. Бактерии попадают в организм человека вместе с зараженными продуктами или через грязные руки.
- Грибковые инфекции. Возбудителем заболевания выступает грибок кандида.
Вирусная кишечная инфекция
Вирусные кишечные бактерии и инфекции передаются воздушно-капельным путем, но нередки случаи заражения через грязные руки или продукты. Диагностировать такую инфекцию бывает сложно по причине ее схожести с простудными заболеваниями. У человека поднимается температура, появляется слабость, насморк, кашель, боли в горле. По этой причине вирусную кишечную инфекции еще называют кишечным гриппом.
Ротавирусная кишечная инфекция, как и другие кишечные инфекции вирусного происхождения, отличается от простуды и гриппа наличием симптомов заболевания ЖКТ. Спустя два-три дня после заражения у больного появляется диарея, рвота, боли в области желудка или кишечника, снижение аппетита. В этот период больной особенно заразен, поэтому ухаживающим за ним людям следует соблюдать меры предосторожности.
Бактериальная инфекция кишечника
Болезнетворные бактерии попадают в организм человека вместе с испорченными или грязными продуктами, через грязные руки, посуду и другие предметы. Кишечные инфекции бактериального происхождения протекают сложнее вирусных кишечных инфекций и несут с собой более серьезные осложнения. Проблема лечения данных заболеваний заключается в том, что большинство кишечных бактерий быстро приспосабливается к антибиотикам и не реагирует на них.
Одной из распространенных среди бактериальных инфекций пищеварительной системы является стафилококковая инфекция в кишечнике. Стафилококк живет в организме человека все время, но в ограниченном количестве. Снижение иммунитета и попадание бактерий стафилококка извне может привести к серьезному заболеванию, которое быстро прогрессирует и тяжело поддается лечению.
Грибковые инфекции кишечника
Грибковая инфекция кишечника поражает слизистую данного органа и вызывает патологические изменения в деятельности всей пищеварительной системы. Основным возбудителем указанной инфекции является кандида. Симптомы и протекание заболевания зависит от формы инфекции:
- Неинвазивный кандидоз. Симптомами данного заболевания являются кишечные расстройства и кожная сыпь.
- Инвазивный кандидоз. Заболевание распространяется на другие органы, приводя к серьезным нарушениям здоровья.

Кишечная инфекция — симптомы
Если у человека развивается инфекция кишечника, симптомы данного заболевания будут такими:
- Болезненные спазмы кишечника. Боли в животе носят острый характер и длятся несколько минут.
- Диарея. Расстройство стула может носить разный характер. При неукротимом поносе следует обратиться в больницу, так как обезвоживание может стать причиной летального исхода.
- Тошнота и рвота. Неукротимая рвота так же опасна, как и неукротимая диарея, так как выводит из организма необходимую жидкость.
- Отсутствие аппетита.
- Высокая температура. При сильной инфекции температура может держаться на высоких цифрах несколько дней.
- Слабость. Этот симптом является следствием обезвоживания, недостатка питательных веществ и высокой температуры.
- Кожные высыпания, зуд. Данный симптом характерен для некоторых видов кишечной инфекции: энтеровируса и грибковой кишечной инфекции.
Расстройство ЖКТ
Острая кишечная инфекция сопровождается расстройством всего желудочно-кишечного тракта. Желудок перестает полноценно функционировать, в результате чего появляются тяжесть и боли в области желудка, отрыжка, изжога. Нарушается перистальтика кишечника, усиливается газообразование, появляется запор или диарея. Названные симптомы будут проявляться в той или иной мере до той поры, пока не будет побеждена инфекция.
Температура при кишечной инфекции
Признаки кишечной инфекции начинают проявлять себя уже со второго дня заражения. Среди первых симптомов заболевания значится повышенная температура. При кишечной инфекции температура поднимается до определенной цифры и удерживается на ней в течение нескольких дней. Зачастую температура останавливается в промежутке 38-38,5 градусов. Врачи рекомендуют сбивать такую температуру жаропонижающими препаратами, чтобы избежать дополнительной потери жидкости.
Сыпь при кишечной инфекции
Инфекционные болезни кишечника, вызванные энтеровирусом, сопровождаются несвойственным кишечным заболеваниям симптомом: сыпью. Кожные высыпания могут располагаться в одном месте тела или же покрывать значительную часть кожи. Изначально поражается кожа лица. Затем к высыпаниям присоединяются другие симптомы заболевания: высокая температура, увеличение лимфоузлов, слабость, расстройство желудочно-кишечного тракта. Данный вид инфекции может иметь тяжелые последствия, поэтому лечение энтеровирусной инфекции лучше проводить в стационаре.
Анализ на кишечные инфекции
Анализ кала и крови помогает определить, какой вирус в кишечнике в даном случае вызвал заболевание. Благодаря этому врач может подобрать эффективный для этого случая лекарственный препарат. Перед сдачей на анализ каловых масс нельзя употреблять энтеросорбенты, антибиотики и слабительные препараты. Анализ кала на кишечные инфекции обрабатывается в течение пяти дней, поэтому в первые дни заболевания врач назначает лекарственные препараты, опираясь на описанную симптоматику.
Кишечная инфекция – лечение
Кишечная инфекция является заразным заболеванием, поэтому во время ее лечения следует изолировать больного от общества. Врачи предлагают такие способы, чем лечить кишечную инфекцию:
- Полный голод, а при невозможности – жесткая диета.
- Употребление регидратационных препаратов.
- Употребление сорбентов.
- Лечение симптомов: высокой температуры, поноса, рвоты.
- Полный покой. Так как больной находится в состоянии голода, он будет ощущать сильную слабость и головные боли. В таком состоянии больному необходимо больше лежать.
- Пить много чистой воды.
Лекарства от кишечной инфекции
Для лечения кишечной инфекции применяются такие фармацевтические препараты:
- Регидратационные препараты: Регидрон, Трисоль. Диарея и рвота приводят к потере необходимой жидкости и солей, поэтому названные солевые растворы призваны поддержать солевой баланс в организме. Солевые растворы можно готовить самостоятельно.
- При сильном поносе и рвоте врачи прибегают к внутривенному вливанию раствора глюкозы и хлорида натрия.
- Употребление сорбентов: Полисорб, Смекта, Энтеросгель, Атоксил. Эти таблетки от инфекции кишечника помогают очистить организм от продуктов распада и вредных веществ, образующихся под воздействием вирусов.
- Антибиотики при кишечной инфекции помогают воздействовать непосредственно на болезнетворную бактерию. Врач может назначить антибиотик до того, как будет готов анализ, чтобы не терять времени. По результатам анализа антибиотик может быть сменен. Эффективными для данного заболевания являются такие антибиотики: Офлоксацин, Норфлоксацин, Ципрофлоксацин, Доксициклин, Левомицетин, Метронидазол.
- Средства для борьбы с диареей: Лоперамид, Фталазол, Имодиум, Фуразолидон.
- Лекарства для снижения температуры: Нурофен, Парацетамол, Анальгин.
- Противорвотное средство применяется при неукротимой рвоте: Церукал. При частой рвоте приходится вводить препарат внутримышечно.
- Ферментативные препараты при кишечной инфекции: Панкреатин, Мезим, Фестал, Креон, Ликреаза. Их начинают употреблять после того, как сняты все острые симптомы.

Лечение кишечных инфекций народными средствами
Инфекция кишечника, лечение и восстановление после болезни, будут затяжными и малоэффективными, если больной не будет соблюдать диету и поддерживать в организме водно-солевой баланс. Ускорить выздоровление помогут такие народные рецепты:
- Настой сушеницы болотной. Предназначен для снятия болевого симптома и синдрома раздраженного желудка, избавления от диареи. Для его приготовления 1 ст.л. травы заливают стаканом кипятка и настаивают 2 часа. Пьют по 150 мл перед едой.
- Отвар корня аира. Поможет при диарее, болезненных ощущениях, воспалении кишечника. Для его приготовления необходимо измельчить 3 ст.л. корней и проварить их полчаса на слабом огне в полулитре воды.
- Солевой раствор. Помогает избежать обезвоживания. На стакан воды добавляют по 1 ст.л. соли и сахара.
- Отвар ромашки. Обладает антисептическими свойствами, помогает бороться с болезнетворными бактериями. Для его приготовления 1 ст.л. сырья заливают стаканом кипятка и удерживают полчаса на водяной бане. Отвар необходимо пить маленькими глотками.
Что можно есть при инфекции кишечника?
Диета при кишечной инфекции является важной составляющей лечения. Чтобы ускорить выздоровление, рекомендуется соблюдать такие правила:
- Диета при инфекции кишечника: отказ от всех жареных, жирных, кислых, консервированных, сладких, молочных и мучных блюд, свежих овощей и фруктов.
- Меню должно состоять из вязких каш, нежирного мяса, киселей, сухариков.
- Следует питаться дробно и часто.
- При возможности в день необходимо выпивать около 2 литров минеральной воды.
Восстановление функции кишечника после инфекции
После кишечной инфекции организм нуждается в восстановлении. Этот период занимает около двух недель. В этот промежуток времени следует выполнять такие рекомендации:
- Соблюдать диету, в которой должны отсутствовать продукты, раздражающие стенки желудочно-кишечного тракта и вызывающие брожение (свежее молоко, кисломолочные продукты, бобовые, злаки, зелень, свежие овощи и фрукты, жареная, копченая, консервированная пища, кофе, чай, алкоголь, сладости и сдоба.).
- Употреблять ферменты: Мезим, Панкреатин, Фестал, Креон, Ликреаза.
Профилактика кишечных инфекций
Вирусная инфекция кишечника может повториться в дальнейшем, если не соблюдать следующие меры предосторожности:
- Необходимо как можно чаще мыть руки.
- Тщательно следить за свежестью продуктов.
- Пить лишь очищенную воду.
- Правильно хранить продукты в холодильнике, соблюдая сроки и товарное соседство.
- При необходимости питаться в проверенных учреждениях общепита.
womanadvice.ru
Вирусные инфекции ЖКТ
ВИРУСНЫЕ ИНФЕКЦИИ ЖКТ
Насчитывается более 200 видов, способных вызывать инфекцию ЖКТ.Передача вируса фекально-оральным путем стоит на 2 месте по частоте после респираторных инфекций.Вирусные болезни ЖКТ составляют около 16% всех вирусных заболеваний. В год возникает около 3 млрд. случаев вирусных заболеваний ЖКТ, из 5-10 млн. заканчивается летально ( в основном среди детей).Это основная причина заболеваемости, смертности детей, особенно до 5 лет. Вирусы этой группы обязаны быть устойчивы к воздействию кислотной и ферментной сред желудка и duodenum. Известно более 200 возбудителей, относящихся к семействам РНК и ДНК-содержащих вирусов, способных реплицироваться в тканях и органах ЖКТ.Большинство из них не вызывают клинических симптомов. Вирусы населяют ЖКТ с первых дней рождения ребенка, и затем на протяжении жизни в тканях и органах ЖКТ многократно происходит репродукция вирусной популяции, сопровождающаяся в разной степени выраженными клиническими симптомами от инапарантных форм до крайне тяжелых. Одни вирусы ограничиваются репликацией в ЖКТ без клинической симптоматики, другие, например полиовирус, используя ЖКТ в качестве входных ворот, вызывают заболевание ЦНС и других органов. Третьи (рвота, адено-,калици- и др. вирусы), ренгицируясь в эпитемиальных клетках ЖКТ, вызывают их серьезную деструкцию, что ведет к появлению таких клинических синдромов, как диаррея, рвота, обезвоживание. Четвертая группа вирусов, вызывающая системные заболевания (корь, ЦМВ, СПИД) может размножаться в клетках ЖКТ, так же вызывая симптомы энтерита.Около 50 вирусов вызывают в разной степени выраженную патологию у детей и служат причиной возникновения вспышек заболеваемости, часто с высокой летальностью. В последние годы в нашей стране установилась высокая тенденция к росту заболеваемости, в частности ротавирусами и вирусными гепатитами. В стране первой ликвидирующей полиомиелит, вновь появляются спорадические случаи и вспышки (Северный Кавказ) этого грозного заболевания. ВОЗ обьявила о ликвидации полиомиелита в мире к 2000 году, но эта задача представляется малореальной даже в отношении заболеваемости. Скажем к 1996 году в мире выявлено более 6000 случаев паралитического полиомиелита, правда при отсутствии их в Западном полушарии, и тем более решение этой задачи невозможно даже теоретически с точки зрения прадикации диких вирусных популяций. Вялые параличи может вызвать энтеровирус 71. Полиовирус относится к роду энтеровирус семейства Picornoviridae. Это мелкий диаметр 20-30 нм, безоболочный вирус. Энтеровирусы семейства Picornoviridae так же включают вирусы Коксаки А и В, эхо-вирусы.
Вирусы Коксаки разделяют на две группы коксаки А и В с 29 серотипами. Причем коксаки А- это 23 серотипа, а коксаки В- 6 серотипов. В отношении коксаки-вирусов установлено родство некоторое с эхо-вирусами. В патологии человека существенную роль играет 24 серотипа коксаки-А, вызывающие эпидемии коньюктивита. 9 тип коксаки А связан со вспышками менингита и полиомиелито-подобных заболеваний: 16 тип вызывает экзему конечностей. Вирусы коксаки В могут служить причиной возникновения диарреи, панкреотита и как следствие, диабета, менингита, миокардита, эндокардита, перикардита, хронических кардиоваскулярных заболеваний. Многочисленные эхо-вирусы или как их еще называют “ сиротские вирусы”, служат причиной заболеваемости новорожденных, у которых вызывают диарреи, менингит, энцефалит, миокардит,экзантему, но в большинстве случаев инфекция протекает все-таки инапарантн. Известны серотипы 1,9,11,27,29,31. Носителями эхо-вируса являются от 7% детей США до 50% — в тропиках. Пик активности в умеренной поясе — лето, ранняя осень. Эхо- вирусы составляют до 60% всех вирусов изолируемых из ЖКТ. В последние годы выявлено тяжелое энтеровирусное заболевание острый энтеровирусный цвеит и сверхострый энтеровирусный некроз печени. Эти заболевания этиологически связаны с вирусами эхо- 11 и 19 типов. 70 тип энтеровирусов вызывает геморрагический цвеит, 30 тип-менингит, 71 тип служит причиной возникновения эпидемического менингита. Эти вспышки часто возникают в лагерях новобранцев. Вирусы краснухи из рода Рубивирус семейства Тогавириде и паротита рода Рубулевирус семейства парамиксовириде помимо основных хорошо известных клинических синдромов способны вызывать панкреотит с последующим развитием диабета. Исследования последних лет указывают на существенную роль вирусов, в частности коксаки В, в этиологии диабета. В одних случаях происходит прямая деструкция островков Лангерганса с цитолизом бета-клеток, в других постепенная потеря функции . Наблюдается прямая связь конгенитальной краснухи с развитием диабета. Вирус индуцирует аутоиммунную реакцию против бета-клеток с длительным доклиническим продромом и служит спусковым крючком развития инсулинзависимого диабета.С помощью моноклональных антител обнаружен домен капсидного протеида вируса краснухи, имеющий сходство со сходными структурами протеида бета-клеток. Эти данные обьясняют по крайней мере один из механизмов диабета.Астровирусы-это мелкие, РНК-содержащие, диаметр около 30нм вирусы причастны к возникновению легкопротекающей диарреи у новорожденных, в основном в зимне-весенний период. Инкубация 3-4 дня. Вспышки выявлены не только среди детей, а так же и в домах для престарелых. Вирусы помимо детишек изолированы так же от телят, ягнят, поросят, котят, щенят, утят, гусят. Известно 5 серотипов вирусов. 75% заболеваемости детей, астровирусами связано с серотипом 5. К 4 годам 65% детей, а к 10 годам до 90% имеют антитела к астровирусам. Заболеваемость распространения повсеместно в мире. Но составляет менее 3% госпитализированных инфекционыых больных. Вспышки гастроэнтеритов у детей могут вызывать и коронавирусы, передающиеся респираторным путем и затем уже вторично попадая в ЖКТ. Обычно кишечные заболевания связанные с коронавирусами трудно диагностировать.
Вирусы гриппа спорадически могут вызывать гастроэнтериты. Напомним, что вирусы гриппа являются основной инфекцией у птиц, и там они являются типичными энтеровирусами с фекально-оралной передачей. Ротавирусы из семейства реовириде служат причиной возникновения от 30 до 50% гастроэнтеритов детей до 4-х летнего возраста, а зимой -90% всех энтеритов связано с ротавирусами. Они являются важной причиной смертности у детей до 4-х лет. Это высококонтагиозноая инфекция т.е. для заражения требуется минимальная инфекционная доза. Заражение фекально-оральным путем. Вирус выделяется от 2 до 6 дней после начала заболевания. Диаррея длится от 1 до 9 дней. Для изоляции из образцов стула используются первичные культуры клеток почек зеленой мартышки. Для диагностики используется электронная микроскопия, иммунофлюоресцентная преципитация, ИФА. Рвота-96%, лихорадка-80%, обезвоживание-75%, летаргия-35%, ангина-до 50%,насморк-25%. Ротавирусы имеют повсеместное распространение и подразделяются на ряд групп.Ротавирусы найдены у крупного рогатого скота, свиней, коз. Поражается главным образом duodenum. Описаны случаи ротавирусного абцесса печени. У больных детей обнаруживается в 1 гр. фекалий до 10 млн вирусных частиц. Ежегодно в мире переболевает около 18 млн людей. Большинство взрослых людей имеют антитела.
Ряд типов аденовирусов вызывают гастроэнтериты у детей, заболевание плода.1 г. фекалий содержит до 10, а иногда до 100 млн инфекционных частиц. Вирусы распространены повсеместно. Являются причиной диарреи от 7 до 17% госпитализированных детей. Часто ассоциируется с респираторным синдромом. Чаще среди детей младшего возраста (от 6 мес. до 2 лет).Частые внутригоспитальные инфекции, среди новобранцев. Инкубация 7-8 дней, диаррея длится 8-12 дней, экскреция вируса может быть и дольше.
Гастроэнтериты у детей младшего возраста часто протекающие с мезентериальноым синдромом вызывают аденовирусы 12,18,31 серотипов. Диагносцируются очень сложно. Вспышки не имеют сезонности. У младенцев может развиваться мезентериальный лимфаденит. В кишечный тракт вирус проникает через верхние дыхательные пути. Заболевание по сравнению с ротавиусной инфекцией протекает менее остро, без летальности, но затягивается. Мезадениты иногда дают картину острого живота и приводят к инвагинации. Аденовирусами поражается главным образом тонкая кишка.
Передающейся фекаль-оральным путем паровирус В19 рода паровирус семейства паровириде, как показали последниеиследования, может служить причиной инфекционной эритемы, заболеваний плода, печени,панкриотита. Особенно велико значение вируса мелкого, диаметр 27-35 нм., входящего в семейство калицивириде. Частота возникновения диарреи 98%, тяжелой формы ( до 10 раз в день), рвота практически-90%, рвота до 6 раз в день- 50%. Известно 4 серотипа. Диагноз очень трудны. Взрослые имеют антитела в 60%. Эти вирусы обладают очень высокой стабильностью, служат причиной 2/3 всех небактериальных гастроэнтеритов у детей школьного возраста. Заболевание нередко сопровождается везикулярной экзантемой.Установлено повсеместное распространение вируса.1/3 вспышек проходит весной, 1/3-летом, и по 20% приходится на осень и зиму.Заражение фекально-оральное через грязную воду, продукты питания.Среди взрослых вспышки инфекции чаще всего возникают в семьях, армейских коллективах, туристических лагерях. Инкубация 12-48 часов. У 30-40% лихорадка,головные боли, часто тошнота.
ВГА относится к семейству пикорновириде, род хепатовирус, он является безоболочным РНК-содержащим вирусом, специфическим,диаметр 27-28 нм. обладает высокой степенью гепатотропности, уникальной термостабильностью.Изолировано 7 подтипов, из которых 4 изолировано от людей, а 3-от обезьян.Вирус распространен повсеместно, но особенно велик риск заражения в жарких странах, где велик дефицит воды, плохая система канализации, неудовлетворительным санитарно-гигиеническим состоянием. В таких регионах болеют преимущественно дети, а в развитых странах болеют и взрослые. В странах Центральной и Северной Европы лишь 20-40% взрослого населения имеют антитела, в Восточной и Южной Европе -80-90%,в Южной и Центральной Америке-80%, в Юго-Восточной Азии практически 100% населения старше 5-10 лет инфицировано гепатитом А. 1 гр. фекалий содержит до 100 млн. инфекционных доз. Для гепатита А характерны эпидемические вспышки. Например в Шанхае в 1988 году сразу заболело более 300 тыс.чел. Смертность не превышает 0,1-0,5%. Фульминантных форм практически не бывает. Хронизации процесса практически то же не бывает.В бывшем СССР ВГА составлял до 90% заболеваемости всеми острыми гепатитами, заболеваемость достигла 270-280 на 100тыс. населения. не менеее 1/3 от всего количества больных составляли жители Средней Азии. В Москве антитела обнаружились у 10% детей 4-6 лет, в 50% в возрастной группе 15-18 лет. В среднеазиатских республиках 70% детей имели антитела, а после 14 лет- практически 100% т.к. 1 гр. фекалий содержит 100 млн инфекционных доз, то никакие введения гаммоглобулина не в состоянии повлиять на заболеваемость гепатитом А. Гаммоглобулин охраняет ребенка в лучшем случае до 3-х месяцев, а в таких условиях циркуляция вируса осуществляется круглогодично.В этих местах часто канализация и трубы водоснабжения проходят в одной большой трубе. В таких условиях, чтобы оградить ребенка от заболевания, ему нужно вводить иммуноглобулин по крайней мере 4 раза в году. Это невозможно, без существенных изменений санитарного состояния территории борьба с ВГА представляются обсолютно невозможной.После заражения ВГА репликация вируса происходит в кишечнике, оттуда через портальную вену он проникает в печень. Клиническое течение легкое, а у детей до 5 лет очень часто ассимптомное. У взрослых клинические признаки наблюдаются чаще в 50-80%. Поэтому целесообразно профилактическое введение гаммоглобулина лицам попадающим в гиперэндемичные районы на непродолжительный срок ( туристы, военнослужащие). Продолжительность заболевания 2-3 недели. Фульминантные формы
возникают крайне редко. Вне зависимости от формы заболевания антиген в фекалиях определяется за 5- 7, а в отдельных случаях за 14
дней до повышения активности печеночных ферментов, а
продолжается 1-10 дней после этого повышения. Повреждение
гепатитов возникает не за счет прямого цитопотатического действия, а результате иммунопатологичских реакций.После инфекции возникает пожизненный гуморальный и местный иммунитет. Профилактика заболевания должна быть напралена на улучшение прежде всего общего санитарно-гигиенического состояния района. Пассивная иммунопрофилактика возможна для лиц, направляющихся в гиперэндемичные районы на срок не более 3- месяцев. Разработаны инактивированная, атенуированная и рекомбинантная вакцины, которые создают неплохую защиту.Сейчас разрабатываются и комбинированные вакцины против ВГА и ВГВ. Однако вирусологи сомневаются в целесообразности вакцинации против ВГА. Вакциная нужна только на тех территориях, которые не являются гиперэндемичными по гепатиту А, а так же для отдельных контингентов.
ГЕПАТИТ Е (ВГЕ)
Вирус относится к семейству калицивиде, роду хепавирус. Является безоболочным РНК-содержащим вирусом, специфической формы, диаметр 32-34 нм. Возможно, что вместе с вирусом краснухи и некоторыми другими вирусами ВГЕ будет выделен в отдельное семейство.Заражение ВГЕ происходит в основном через контаминированную фекалиями воду. По сравнению с ВГА заражающая доза ВГЕ существенно выше, соответственно эпидемии ВГЕ возникают при серьезном загрязнении воды. Гиперэндемичные районы расположены в основном в странах экваториального и торопического климата (Экваториальная зона Африки и Латинской Америки,Юго-Восточная Азия).Эпидемии могут иногда охватывать десятки, а иногда сотни тысяч человек. Доля ВГЕ среди всех гепатитов в Средней Азии 40-50% и более, что связано с нарушением санитарных условий существования населения. На отдельной терртории встречаются лишь спорадические случаи заболевания. Эндемичные районы расположены в низменных областях хлопководства. Эпидемии как правило возникают после подьема грунтовых вод, селей и т.д. Пик заболеваемости наблюдается в октябре- ноябре ( период сбора хлопка). Поражаются как правило люди в возрасте 15-70 лет ( работники хлопковых плантаций). Еще один признак -низкая семейная заболеваемость. Характерна высокая смертность (до 10% ) среди беременных женщин во второй половине беременности. Имеются диагностические тес- системы. Течение обычно легче чем при ВГА ( за исключением беременных) хронизации практически нет. ВГЕ был изучен профессором Балаяном путем самозаражения. У беременных женщин легкая форма встречается в 20%, средняя в 60% тяжелая в 25% случаев. У остальных людей преобладают легкие формы (60%). В тяжелых случаях наблюдается гемоглобинурия (90%), острая почечная недостаточность(50%).Профилактика- улучшение снабжения качественной питьевой водой. Имеются цельновирионные, рекомбинантные вакцины.
studfiles.net
Кишечные вирусные инфекции у детей
Кишечные вирусные инфекции у детей
Главная страница → Пациентам → Кишечные вирусные инфекции у детейСологуб Т.В. – профессор, заслуженный врач России, главный инфекционист СЗФО, зав. кафедрой инфекционных болезней СПбГМА им. И.И.Мечникова, доктор медицинских наук, академик МАНЭБ.
Острые кишечные инфекции были и остаются одной из важнейших проблем как отечественной, так и зарубежной инфектологии. При этом в подавляющем большинстве случаев, инфекционные заболевания, протекающие с синдромом поражения ЖКТ, вызываются вирусными агентами. Так, по данным ВОЗ, на долю вирусных инфекций приходится 70% всех ОКИ, в то время, как число ОКИ бактериальной этиологии составляет не более 30%. Ротавирус, по сведениям разных авторов, является причиной 20-60% ОКИ у детей, а заболеваемость норовирусной инфекцией занимает второе место в структуре всех ОКИ и составляет порядка 25% случаев.
Кишечные вирусные инфекции поражают преимущественно детей раннего возраста (до 3 лет), а также лиц старше 60 лет. Рядом авторов отмечается увеличение числа случаев заболеваемости ротавирусной инфекцией, при сохраняющейся тенденции к гиподиагностике, однако динамика показателей заболеваемости неодинакова для разных регионов. Так, по Москве, по данным Федеральной службы по надзору в сфере защиты прав потребителей и благополучия человека в первом полугодии 2007 года отмечено снижение показателей заболеваемости ротавирусной инфекцией на 11,9% по сравнению с аналогичным периодом прошлого года за первое полугодие 2007 года составил 14,67 на 100 000 населения. Возрастная структура заболеваемости соответствовала общим тенденциям. Наибольшие показатели заболеваемости зарегистрированы (в порядке убывания) в возрастной группе от 1 до 2 лет, среди детей в возрасте до 1 года и детей от 3 до 6 лет.
Этиология
Открытие ротавирусавируса произошло в 1973 году, а в 1979 ВОЗ официально утвердила его название, происходящее от латинского «rota» –колесо, из-за схожести вирусной частицы с колесом при микроскопии.
Ротавирусы делятся на пять групп: A, B, C, D, E, среди которых основное эпидемиологическое значение имеет ротавирус группы А. Вирус устойчив к действию обычных дезинфектантов, в течение длительного времени сохраняется во внешней среде, однако разрушается при кипячении и обработке сильными кислотами и щелочами.
Норовирус впервые был обнаружен в 1972 году в США, штат Норфолк, от чего и произошло его первоначальное название Норфолк вирус. Ранее заболевание, вызываемое норовирусом, связывали с употреблением в пищу недоброкачественных продуктов, в частности моллюсков и других морепродуктов.
Инфекция широко распространена в США, Австралии, Японии, Великобритании и других странах. По различным данным, антитела к норовирусу определяются у 50-70% взрослого населения, в разных странах.
Норовирус относится к семейству кальцивирусов. Вирус устойчив во внешней среде и легко передается через прикосновения.
Эпидемиология
Кишечные вирусные инфекции широко распространены во всех странах мира. Источником инфекции является только больной человек, штаммы, встречающиеся у животных, не представляют для человека эпидемиологической опасности. Механизм передачи – фекально-оральный, реализующийся контактным, водным и алиментарным путями. Возможность передачи инфекции воздушно-капельным путем в настоящее время дискутируется, но большинством авторов отвергается.
Для рота- и норовирусной инфекции характерна осеннее — зимняя сезонность, причины которой остаются до конца не изученными. По-видимому, данные вирусы более устойчивы во внешней среде при низких температурах. Кроме того, в зимние месяцы отмечаются явления иммунодефицита, что также благоприятствует распространению вируса. Спорадические случаи заболевания регистрируются также и в летний период.
Болеют преимущественно дети раннего возраста, среди детей старше 11 лет заболеваемость значительно снижается и вновь возрастает в возрастной группе от 60 лет и старше. Следует отметить, что у детей младше 6 месяцев, особенно находящихся на естественном вскармливании, кишечные вирусные инфекции встречаются реже, чем в возрастной группе от 6 месяцев до 3 лет, что, по-видимому, связано с передачей антител к вирусу от матери ребенку и с грудным молоком. У более старших детей, при снижении напряженности иммунитета, заболевание наступает значительно чаще. Чрезвычайно высокая частота обнаружения антител к ротавирусу у детей старшего возраста позволяет достоверно утверждать, что к четырем годам ротавирусную инфекцию переносят до 90% детей. Иммунитет нестойкий, типоспецифический. Большинство детей переносят инфекцию неоднократно, при этом последующие заболевания протекают в более легкой форме, чем первое.
Вспышки рота- и норовирусной инфекции регулярно регистрируются в разных странах. Особенно часто заболевают дети, посещающие детские дошкольные учреждения, что, по-видимому, связано с фекально-оральным механизмом передачи инфекции.
Патогенез
Входными воротами инфекции является желудочно-кишечный тракт. Обладающий «прилипчивостью» к клеткам слизистой оболочки ворсинок тонкой кишки, вирус активно размножается. В результате вирусной активности клетки слизистой оболочки слущиваются и выходят с каловыми массами. Верхушки ворсинок обнажаются и отекают; впоследствии слушенные клетки замещаеются функционально незрелыми клетками, что, в свою очередь, приводит к возникновению дисахаридазной, преимущественно лактазной, недостаточности. В результате этого происходит накопление нерасщепленных дисахаридов, повышение осмотического давления. В связи с этим жидкость и электролиты выделяются, что в результате и приводит к потере жидкости.
Клинические проявления
Выделяют следующие клинические варианты течения кишечных вирусных инфекций:гастритический, гастроэнтеритический, гастроэнтероколитический, энтеритический и энтероколитический. Наиболее часто встречается гастроэнтеритический вариант, реже – гастритический.
Инкубационный период составляет 1-2, реже до 4 дней. Заболевание начинается остро, с подъема температуры до 37,5-38,0 С, при более тяжелых формах – до 39С и выше. Отмечается интоксикационный синдром, характеризующийся слабостью, вялостью, снижением аппетита. У грудных детей возможно появление «мраморного» рисунка кожи.
В начальном периоде заболевания некоторыми авторами отмечаются катаральные явления: гиперемия и отечность зева, мягкого неба, инъекция сосудов склер, ринит. Возможно увеличение шейных лимфатических узлов. В дальнейшем возникают симптомы поражения ЖКТ, характерные для гастроэнтеритического синдрома: тошнота, повторная рвота, диарея, боли в эпигастральной области. У значительного числа больных определяется выраженное урчание в правой подвздошной области.
Характерно одновременное появление всех симптомов поражения ЖКТ. Лишь у незначительного числа больных понос и рвота возникают на второй — третий день болезни. В большинстве случаев заболевание протекает с синдромом гастроэнтерита, реже — с гастритическим синдромом.
Для кишечных вирусных инфекций характерен обильный пенистый стул желтоватого или зеленоватого цвета, в дальнейшем приобретающий вид «рисового отвара» и напоминающего стул при холере. Частота дефекаций редко составляет более 10-12 в сутки. При легких формах заболевания стул может быть кашицеобразным. Патологические примеси в кале, как правило, отсутствуют. Наличие таковых может свидетельствовать о наличии микст-инфекции либо являться показателем возникновения энтероколитического синдрома (примерно у 20% детей).
Следует отметить, что течение заболевания неодинаково в разных возрастных группах. Так, у детей младше трех месяцев кишечные вирусные инфекции протекают, как правило, в легкой форме. В группе от 3 месяцев до 2-х лет наблюдается среднетяжелое течение. У этих больных отмечается сильная интоксикация, а синдром поражения ЖКТ — средней выраженности. Для детей старше 2-х лет характерно более легкое и короткое течение болезни.
Диагностика данного заболевания у новорожденных затруднена. Из клинических признаков можно отметить беспокойство, крик, отказ от пищи, резкую потерю в весе, урчание в правой подвздошной области.
Дегидратация (потеря жидкости в организме) характерна для данного заболевания, однако она редко бывает выраженной. Осложнения, связанные преимущественно с дегидратацией, возникают редко.
Лечение
Специфической противовирусной терапии рота- и норовирусной инфекций не разработано. Всем больным, вне зависимости от тяжести течения заболевания, рекомендуется назначение низколактазной диеты. При этом для детей, находящихся на грудном вскармливании, доля молока сокращается до 50%, при искусственном – осуществляется перевод на кисломолочные или соевые смеси. В качестве прикорма используются безмолочные каши на воде, овощные и мясные пюре. Исключаются продукты, содержащие большое количество углеводов, в частности фруктовые пюре и соки.
Применяется патогенетическая терапия, направленная на восстановление потери жидкости (регидратации). С целью пероральной регидратации при легкой форме заболевания возможно применение глюкозо — солевых растворов (регидрон и др.), при среднетяжелой и тяжелой формах целесообразно назначение терапии кристаллоидными растворами (трисоль, ацесоль, квартасоль и др.). Детям с раннего возраста можно назначать Энтеросгель, Смекту, Зостерин ультра. Полезным в плане лечения больных кишечными инфекциями является назначение пребиотиков. Детям с трех лет для дезинтоксикации организма назначается Рекицен-РД. Препарат Рекицен-РД выполняет две взаимодополняющих друг друга функции — проводит эффективную глубокую очистку организма и одновременно насыщает организм большим количеством ценнейших биологически активных веществ, входящих в его состав, которые являются селективным питанием для нормальной микрофлоры кишечника. Препарат восстанавливает пищеварение при заболеваниях печени, желудка и кишечника, нормализует стул, устраняет явления изжоги. Действие препарата обусловлено тем, что он связывает и выводит из организма токсины различного происхождения и нормализует консистенцию стула. Детям назначают Рекицен-РД по 1 чайной ложке три раза в день за 30 минут до еды, либо добавляют его в пищу. Кроме того с целью восстановления микрофлоры кишечника можно использовать пробиотики (бифиформ, бифидумбактерин, лактобактерин, бактисубтил, споробактерин, линекс, хилак форте, Бифидум 791 БАГ, Трилакт, Экофлор и др.). Бифидум 791 БАГ — живые активные бифидобактерии, 1000 фармакопейных доз в 1 фл. 10 мл, разрешен для новорожденных детей с первого дня жизни, не содержит консервантов и стабилизаторов. Трилакт — комплекс живых активных лактобактерий. Эффективное средство профилактии вирусных инфекций, гриппа, природный «антибиотик», мощный иммуностимулятор, естественный биосорбент. Экофлор — комплекс живых антагонистически активных натуральных штаммов бифидо- и лактобактерий, закрепленных на поверхности углеродминерального сорбента СУМС-I, который обепечивает защиту бактерий при прохождении их через кислую среду желудка и обладает высокой адсорбционной активностью в отношении токсинов различного происхождения. СУМС — I обеспечивает выведение из организма солей тяжелых металлов, избирательную адсорбцию токсинов, не нарушает водно-солевой баланс, не вызывает ослабление тонуса мышц кишечника, не выводит ферменты, гормоны, транспортные белки, а также сероводород, необходимый для перистальтики. При попадании сорбента в кишечник бактерии открепляются от сорбента. При этом они находятся в активном физиологическом состоянии. Это помогает им заселять слизистую кишеника, и существенно повышает антагонистическую активность.
Профилактика
Специфической профилактики кишечных вирусных инфекций не разработано. К мерам неспецифической профилактики можно отнести своевременное выявление и изоляцию инфицированных детей, тщательную санитарно-гигиеническую обработку предметов общего пользования, контроль качества воды и продуктов питания в детских учреждениях.
Все дети, перенесшие кишечную вирусную инфекцию, подлежат диспансеризации, последующим контролем выделения вируса.
Комментарии
normoflora.com
Вирусная кишечная инфекция: возбудители заражения
Вирусы подстерегают человека повсюду. Не спрятаться от микроскопических врагов ни дома, ни на работе, ни в дошкольных заведениях, ни в школе. Эти не видимые глазу микроорганизмы способны нанести значительный вред здоровью. Как же распознать и обезвредить вирусную кишечную инфекцию?
В кишечнике любого человека существуют различные микроорганизмы
Как проявляются заболевания
Инкубационный период составляет от 15 часов до 5 суток. Подавляющее число пациентов отмечает у себя характерные симптомы уже в первые сутки после попадания вируса в организм:
- Жидкий стул. Желтые испражнения приобретают водянистую консистенцию со следами пены. Частота походов в туалет варьируется от 10 до 15 раз в сутки. Длится понос 3-5 дней.
- Рвота нечастая. Обычно рвотные позывы не продолжаются более суток. Но не все больные отмечают у себя этот синдром.
- Боли чувствуются в верхней части брюшной полости, иногда болевые ощущения «растекаются» по всему животу. Больные часто идентифицируют симптом, как дискомфорт в животе.
- Лихорадочное состояние длится 1-7 дней. Температура то поднимается, то приходит в норму. Варьируется в пределах 38°C.
- Интоксикация. Пациенты жалуются на слабость, головокружение, потерю аппетита, кратковременные обмороки.
Вирусные кишечные инфекции могут спровоцировать ацетономическую рвоту у детей. Ацетон в моче появляется как реакция на перегрузку детского организма.
Возбудители инфекций обосновываются не только в пищеварительном тракте, но и в других системах. Например, энтеровирусы провоцируют высыпания на конечностях, появление прозрачных пузырьков в зеве, увеличение печени.
Возбудители кишечных расстройств
Кишечные инфекции вирусной этиологии чаще всего вызываются ротавирусами. Самыми опасными для здоровья человека являются представители группы А. Именно они оседают в верхнем отделе тонкого кишечника и вызывают заболевание.
Ротавирусная инфекция является очень опасным заболеванием, в особенности для детей
Второе место по частоте заболеваемости принадлежит аденовирусам. Большинство из них выбирают для жизни верхние дыхательные пути, а вот расстройства кишечника вызывают только два штамма. В каждую пораженную клетку может уместиться около 1 миллиона вирусов.
Немного реже острые кишечные расстройства вызывают энтеровирусы и реовирусы.
Все болезнетворные вирусы не боятся низких температур. Аденовирусы отлично переносят даже замораживание. Также все штаммы отличаются кислотоустойчивостью, а энтеровирусы превосходно сохраняют жизнедеятельность в воде.
Симптомы схожи, а болезни разные
Желудочно-кишечные расстройства у человека вызывают не только вирусы. Поселиться внутри стремятся также бактерии. Клиническая картина бактериальных и вирусных заражений во многих чертах сходна. У больных присутствует:
- повышенная температура;
- понос;
- рвота.
Сравнительная характеристика показывает, что проявление симптомов имеет свои особенности. Например, реакция организма на внедрение врага — повышение температуры тела. При атаке вируса температура поднимается резко, часто до появления других симптомов. При попадании в кишечник бактерий, больного начинают беспокоить понос и рвота, а затем лихорадка.
Жидкий стул отмечается в обоих случаях. При вирусном заражении он пенистый, водянистый, окрашен в желтый цвет. При бактериальном — содержит следы слизи, крови, имеет зеленоватый оттенок.
Симптомы вируса и бактериальной инфекции нелегко различить
Пути проникновения
Как же попадают инфекционные агенты в организм? Эти микроорганизмы достаточно изобретательны, поэтому нашли много способов, чтобы обосноваться внутри человека:
- Контактно-бытовой. Попадают после прикасания человека к больному человеку или животному, при контакте с инфицированными поверхностями (посуда, ручка двери, белье). Часто дети, которые посещают детские сады, становятся жертвами заражения именно таким способом.
- Воздушно-капельный. Штаммы проникают внутрь по дыхательным путям. С воздухом в носовые ходы попадают мельчайшие капельки выделений больного. Выбрасываются они в окружающую среду при кашле или чихании.
- Пищевой. Источником заразы становятся плохо обработанные термически мясо и рыба, недостаточно промытые овощи и фрукты. Нарушение правил хранения продуктов в холодильнике тоже чревато печальными последствиями.
- Орально-фекальный. Заражение происходит через продукты и предметы, загрязненные фекалиями. Переносчиками заразы становятся мухи, которые питаются нечистотами.
- Водный. Инфицирование происходит при употреблении сырой воды из колодцев или водоемов. Нарушение правил дезинфекции на водоочистных станциях становится причиной эпидемий.
Такая кишечная инфекция у детей встречается чаще, чем у взрослых. И это неудивительно, ведь желудочный сок, который является главным защитником пищеварительного тракта, у малышей имеет недостаточно высокую кислотность, чтобы бороться с врагом.
Особенно подвержены риску заражения дети до 3 лет. Иммунитет у детского организма еще недостаточно окреп, а правила личной гигиены малыши только начинают познавать.
Маленький организм наиболее подвержен проникновению инфекции
Первая помощь
При появлении заболевания не стоит заниматься самолечением. Бесконтрольный прием лекарственных препаратов становится причиной серьезных осложнений кишечных инфекций. Больного обязательно необходимо показать врачу.
Главным фактором риска при инфицировании является обезвоживание. До посещения доктора важно принять меры по обеспечению организма влагой. Пить необходимо маленькими порциями, но часто. Лучше всего использовать:
- кипяченую теплую воду;
- отвар ромашки;
- раствор Регидрона.
Категорически запрещено использовать лекарства, которые оказывают закрепляющий эффект. Понос — это одно из средств защиты организма. С его помощью вредные вирусы выводятся из кишечника.
Комплексное лечение — залог выздоровления
Лечится такая инфекция так же, как и ОРВИ. Основой терапии являются противовирусные и общеукрепляющие препараты.
Обязательное условие для скорейшего выздоровления — поддержание оптимального водно-солевого баланса. Питьевой режим необходимо соблюдать на протяжении всего лечения.
Вирусы повреждают слизистую оболочку кишечника, поэтому ему не хватает ферментов для полного переваривания пищи. Восстанавливают микрофлору пробиотики — препараты, которые помогают полезным бактериям жить и размножаться.
Правильно назначенное лечение способствует быстрому восстановлению организма
Соблюдение диеты имеет огромное значение. Из рациона необходимо исключить продукты, которые активизируют перистальтику, например, молоко. Вместо него диета разрешает употреблять кисломолочные продукты.
Диета основана на блюдах, которые не раздражают пищеварительный тракт. Пищу готовят на пару или варят. Затем перетирают до полужидкого состояния и теплой съедают. Режим питания при диете составляет 5-6 раз в день небольшими порциями.
Диета для детей первого года жизни имеет свои особенности. Если ребенок находится на искусственном вскармливании, следует заменить привычную молочную смесь на продукт с полным отсутствием лактозы.
Грудничкам матери снижают норму потребления грудного молока за одно кормление на 40%. Больше уменьшать порцию врачи не рекомендуют, потому что у кормящей мамы в молоке находятся антитела, которые усиливают защиту малыша.
У человека, перенесшего данную вирусную инфекцию, вырабатывается относительный иммунитет. Это означает, что защитные антитела будут вырабатываться только для борьбы со штаммом, который активизировал заболевание. По отношению к другим возбудителям иммунитет работать не будет.
Вирусы-невидимки не предупреждают о своем появлении. Поэтому необходимо подготовиться к встрече с ними, соблюдая правила гигиены. Если же заражение произошло, срочно вызывайте врача, и тогда у грозных вирусов не останется ни малейшего шанса навредить.
Имею два образования: техническое и экономическое. Также интересуюсь воспитанием детей, медициной, женскими темами, путешествиями, психологией, а также дизайном и ремонтом.
probakterii.ru